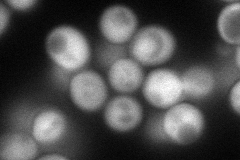
YKL137W
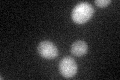
YKL137W

View description
Evolutionarily conserved copper-binding protein of the mitochondrial intermembrane space, may be involved in delivering copper from the matrix to the cytochrome c oxidase complex; contains a twin CX9C motif
Localization:
Intensity:
Fold change:
Significance:
-
C’ GFP library in SD

below threshold19.13 -
N' NOP1pr-GFP in SD
cytosol90.2512 -
N' TEF2pr-mCherry in SD

cytosol105.348 -
N' NATIVEpr-GFP in SD

below threshold26.3457 -
N' TEF2pr-VC and Cyto-VN in SD

mitochondria29.272 -
C’ GFP library in SD+DTT
cytosol19.020.99No -
C’ GFP library in SD+H2O2

cytosol19.931.04No -
C’ GFP library in Starvation Media

cytosol18.310.95No -
C’ GFP library on the background of Pup2-DaMP

below threshold -
C’ GFP library on the background of CCT mutant

below threshold15.74190.8225No
